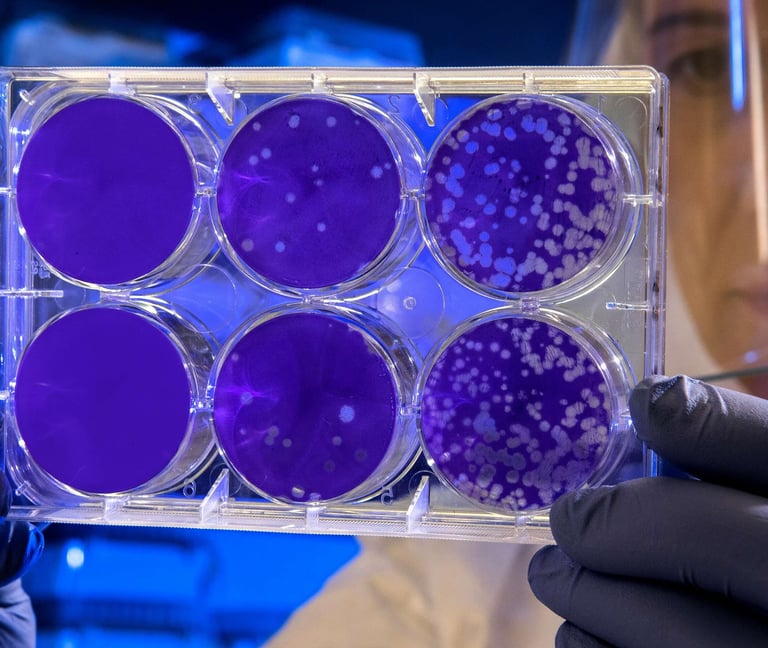
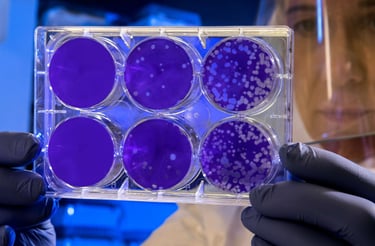

Українське товариство дослідників раку
Організація
УТДР для науковців, медиків, викладачів та аспірантів


Для онкологів
Об’єднуємо фахівців з експериментальної та клінічної онкології на базі інституту ім. Р.Є. Кавецького.




CANCER RESEARCH
ONCOLOGY ONCOLO
UKRAINIAN SOCIETY
ONCOLOGY UTDR CA
14-15 листопада 2025
Конференція з раку простати MOVEMBER-2025
Проєкт ONcoLogiСa
За ініціативи молодих вчених ГО «Українське товариство дослідників раку» започатковано науково-просвітницький проєкт «ONcoLogiСa» спрямований на популяризацію сучасних знань та досягнень у галузі онкології.
Науковці у сфері онкології
Якщо Ви досвідчений науковець, лікар, провідний спеціаліст у галузі клінічної та експериментальної онкології, маєте суміжні інтереси або тільки розпочинаєте свою науково-практичну кар’єру, запрошуємо Вас долучитись до нашої команди!
Про УТДР
ГО «Українське товариство дослідників раку» (ГО «УТДР») – всеукраїнське добровільне об’єднання громадян (науковців, медиків, викладачів, аспірантів та інших фахівців) в галузі експериментальної та клінічної онкології.
Наша мета
Головна мета діяльності ГО «УТДР» є об'єднання її членів задля
популяризації наукових досягнень,
координації фундаментальних та прикладних досліджень раку,
організації науково-практичних заходів,
публікації наукових та науково-популярних видань,
просвітницька робота,
сприяння обміну досвідом між спеціалістами та допомога в інтеграції вітчизняної науки у світовий науковий простір.

Голова УТДР
Керівним органом ГО «УТДР» є Правління Організації, яку очолює доктор медичних наук, професор, академік НАН України Чехун Василь Федорович.



Підвищення професійного рівня
Багаторічний досвід в сфері онкології, медицини та біології, потужний науковий потенціал, співпраця з всесвітньовідомими фахівцями, відкритість та прагнення до підвищення професійного рівня - це те, що ми пропонуємо Вам сьогодні.
Наш внесок
у розвиток української онкології в період великих випробувань для країни
Популяризація онкології
Розповсюдження результатів наукових досліджень в галузі експериментальної та клінічної онкології. Просвітницька робота щодо скринінгу, профілактики онкологічної патології і реабілітації онкохворих.


Впровадження в практику
Сприяння координації фундаментальних і прикладних досліджень та їх впровадження в клінічну практику.
Організація, участь та проведення наукових з'їздів, конференцій, симпозіумів, шкіл-семінарів, майстер-класів тощо, присвячених проблемам онкології на національному та міжнародному рівнях.
Івенти




Публікації
Підтримка видання публікацій у журналах Experimental oncology та Онкологія, а також науково-популярних брошур і монографій.


Експертна допомога
Надання експертної та науково-методичної допомоги науковцям, клінічним онкологам та викладачам навчальних закладів медико-біологічного профілю.
Сприяння інтеграції науки у світовий науковий простір, обмін досвідом та співпраця з зарубіжними науковими установами, товариствами, фондами тощо.
Інтеграція




Піднесення української онкології
У період великих випробувань для України, ми створюємо сильну команду найкращих професіоналів для піднесення престижу вітчизняної онкологічної науки і разом будемо впевнено рухатись в світовий простір безстрашних борців раку!



















